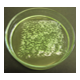

樹脂溶解剤『レジンクリーナー』シリーズ
各種樹脂に対応した、作業環境に優しい洗浄剤
本製品は、接着剤・粘着剤・成形樹脂・コーティング材など、各種樹脂に対応した環境配慮型の溶解・剥離型洗浄剤です。 用途や樹脂の種類に合わせて専用グレードをラインナップしており、洗浄効率と安全性を両立しました。 毒劇物・特化則・有機則・PRTR法に概ね非該当で、作業者の健康にも配慮。 塩素系・芳香族フリーでありながら、優れた溶解力を発揮します。 さらに水溶性タイプ(※一部除く)のため、水ですすぐだけで簡単に後処理でき、環境負荷を大幅に低減します。
基本情報
詳しくはカタログダウンロードまたはお気軽にお問い合わせください
価格情報
各種(~数万円/kg) 各種グレードにより価格が異なります。ご希望の製品について、お問い合わせ下さい。
納期
型番・ブランド名
レジンクリーナー
用途/実績例
当社のレジンクリーナーは、さまざまな業界で信頼を得ています。 接着剤・粘着剤の溶解・洗浄除去 → フィルム加工・電子部品製造などで使用実績多数。 成形機・モールドデポジット洗浄 → 射出成形機・押出機などの保守に最適。 樹脂成形用金型の洗浄 → 精密金型の再生・延命に貢献。 絶縁封止材の除去(不良解析・リワーク対応) → 電子部品・半導体業界で活用。 塗工・塗装設備、コーティング治具の洗浄 → 光学フィルム、塗装設備のメンテナンスに。 塗装・コーティング樹脂の剥離作業 → 再利用・リサイクルを容易にし、環境負荷を削減。
カタログ(1)
カタログをまとめてダウンロードおすすめ製品
取り扱い会社
(株)日新化学研究所は高槻本社工場を研究・開発 拠点に薬品の研究・開発に永年の努力を 重ねてきました。界面活性剤の製造技術を基盤に、繊維、伸線、パルプに関連した化学薬剤の新規開発を はじめ、界面活性剤、高分子化学薬剤、油脂 化学応用薬剤などの研究開発を行なっています。 ユーザー様のニーズにマッチしたカスタマイズ商品開発・技術 サービスに努めています。 一般産業用の消泡剤・配管洗浄剤・帯電防止剤・切削用薬剤のラインアップも充実しております。まずは、お気軽にご相談ください。お悩みの症状をまずは弊社にてラボ評価し、最適な薬剤を選定・ご紹介させていただきます。 ※高槻工場の製造スタッフ及び開発技術職を募集中!!! 詳しくは下の青文字の 『株式会社日新化学研究所のホームページへ』をクリック 採用情報をご参照ください。